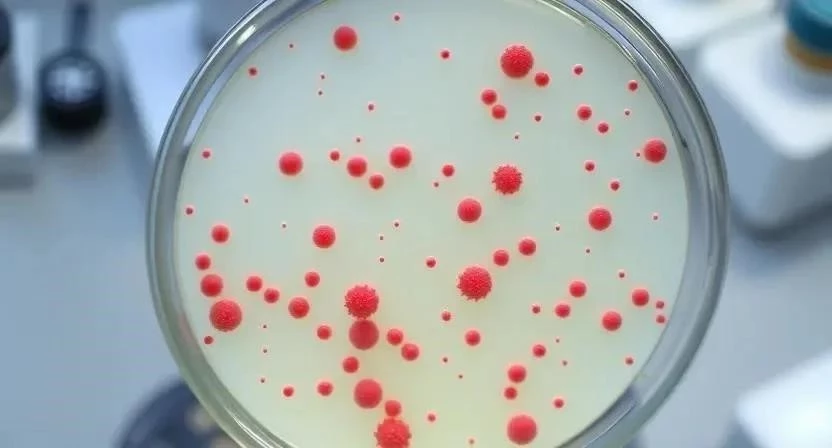

Что будет, если грипп вернется с новой силой? В 2026 году мы можем столкнуться с новыми, более агрессивными штаммами вируса гриппа. По данным Всемирной организации здравоохранения, ежегодно гриппом заболевают до 500 миллионов человек во всем мире. Ключевое слово – грипп 2026. Понимание особенностей новых штаммов и эффективных методов профилактики – залог защиты себя и своих близких от этой опасной инфекции.
Новые штаммы гриппа в 2026 году
В 2026 году ожидается циркуляция нескольких штаммов гриппа, включая варианты A(H1N1), A(H3N2) и различные штаммы гриппа B. Особенностью новых штаммов является их высокая мутагенность, что затрудняет разработку эффективных вакцин. Мутации происходят в гемагглютинин и нейраминидазу – поверхностные белки вируса, которые определяют его способность проникать в клетки и распространяться. Эти изменения могут приводить к снижению эффективности существующих антител, выработанных после предыдущих вакцинаций или перенесенных заболеваний. Появляются данные о возможном появлении рекомбинантных штаммов, содержащих генетический материал от разных вирусов, что делает их еще более непредсказуемыми.
Симптомы гриппа
Грипп – это острое респираторное вирусное заболевание, которое характеризуется внезапным началом и выраженной интоксикацией. Симптомы гриппа могут варьироваться в зависимости от штамма вируса и индивидуальных особенностей организма. Основными симптомами являются высокая температура (выше 38°C), озноб, головная боль, мышечные боли, слабость, сухой кашель, насморк и боль в горле. В отличие от ОРВИ, грипп часто сопровождается более выраженными симптомами и более тяжелым течением. У детей могут наблюдаться тошнота, рвота и диарея. Важно помнить, что самолечение гриппа может быть опасным, поэтому при появлении симптомов необходимо обратиться к врачу.
Диагностика гриппа
Диагностика гриппа включает в себя сбор анамнеза, физикальный осмотр и лабораторные исследования. Наиболее точным методом диагностики является полимеразная цепная реакция (ПЦР), которая позволяет выявить РНК вируса гриппа в мазках из носоглотки. Также используются экспресс-тесты на грипп, которые дают результат в течение 15-30 минут. Однако экспресс-тесты могут быть менее чувствительными, чем ПЦР. Для определения штамма вируса гриппа проводится вирусологическое исследование. Я помню, как однажды перепутал симптомы гриппа с обычной простудой и потерял несколько дней, прежде чем начать адекватное лечение.
Лечение гриппа
Лечение гриппа направлено на облегчение симптомов и предотвращение осложнений. В качестве симптоматического лечения используются жаропонижающие, обезболивающие, противокашлевые и сосудосуживающие препараты. При тяжелом течении гриппа назначаются противовирусные препараты, такие как осельтамивир и занамивир. Эти препараты наиболее эффективны, если начать их прием в первые 48 часов после появления симптомов. Важно соблюдать постельный режим, пить много жидкости и хорошо питаться. Я всегда советую своим близким при первых признаках гриппа немедленно начинать обильное питье и принимать витамин C.
Профилактика гриппа
Профилактика гриппа – это комплекс мер, направленных на снижение риска заражения и распространения вируса. Основным методом профилактики является вакцинация. Вакцина от гриппа содержит инактивированные вирусы, которые стимулируют выработку иммунитета. Вакцинацию рекомендуется проводить ежегодно, так как штаммы вируса гриппа постоянно меняются. Кроме вакцинации, важно соблюдать меры предосторожности, такие как регулярное мытье рук, использование антисептиков, ношение масок в общественных местах, избегание контакта с больными людьми и укрепление иммунитета. Я стараюсь каждый год делать прививку от гриппа, чтобы защитить себя и своих близких.
Грипп у детей
Грипп у детей протекает особенно тяжело, так как иммунная система детей еще не полностью сформирована. Симптомы гриппа у детей могут быть более выраженными, чем у взрослых, и часто сопровождаются высокой температурой, рвотой и диареей. Лечение гриппа у детей должно проводиться под контролем врача. Важно обеспечить ребенку постельный режим, обильное питье и симптоматическое лечение. Вакцинация является наиболее эффективным способом профилактики гриппа у детей. Я помню, как переживал, когда мой ребенок заболел гриппом, и как важно было вовремя обратиться к врачу.
Грипп у взрослых
Грипп у взрослых также может протекать тяжело, особенно у людей с хроническими заболеваниями. Симптомы гриппа у взрослых обычно включают высокую температуру, озноб, головную боль, мышечные боли, слабость, сухой кашель и насморк. Лечение гриппа у взрослых включает симптоматическое лечение и, при необходимости, противовирусные препараты. Вакцинация является наиболее эффективным способом профилактики гриппа у взрослых. Я всегда стараюсь вести здоровый образ жизни и укреплять иммунитет, чтобы снизить риск заражения гриппом.
Осложнения гриппа
Грипп может приводить к различным осложнениям, таким как пневмония, бронхит, отит, синусит, миокардит и энцефалит. Осложнения гриппа чаще возникают у людей с хроническими заболеваниями, пожилых людей и детей. Профилактика осложнений гриппа включает своевременное лечение гриппа, соблюдение постельного режима и укрепление иммунитета. Я знаю случаи, когда грипп приводил к серьезным осложнениям, поэтому всегда призываю своих близких не пренебрегать лечением.

Прогноз заболеваемости
Прогноз заболеваемости гриппом в 2026 году остается неопределенным. Однако, учитывая высокую мутагенность вируса гриппа и возможность появления новых штаммов, можно ожидать, что заболеваемость гриппом будет оставаться на высоком уровне. Рекомендуется проводить мониторинг эпидемиологической ситуации и принимать меры по профилактике гриппа. Я считаю, что важно быть готовым к возможной эпидемии и заранее позаботиться о своей защите.
FAQ
Вопрос: Как часто нужно делать прививку от гриппа?
Ответ: Вакцинацию от гриппа рекомендуется проводить ежегодно, так как штаммы вируса гриппа постоянно меняются.
Вопрос: Какие меры предосторожности следует соблюдать во время эпидемии гриппа?
Ответ: Регулярно мойте руки, используйте антисептики, носите маски в общественных местах, избегайте контакта с больными людьми и укрепляйте иммунитет.
Вопрос: Что делать, если у меня появились симптомы гриппа?
Ответ: Обратитесь к врачу, соблюдайте постельный режим, пейте много жидкости и принимайте симптоматическое лечение.
Вопрос: Какие осложнения могут возникнуть после гриппа?
Ответ: Грипп может приводить к различным осложнениям, таким как пневмония, бронхит, отит, синусит, миокардит и энцефалит.
Вопрос: Как укрепить иммунитет?
Ответ: Ведите здоровый образ жизни, правильно питайтесь, занимайтесь спортом, высыпайтесь и избегайте стрессов.
Вопрос: Можно ли лечить грипп народными средствами?
Ответ: Народные средства могут помочь облегчить симптомы гриппа, но они не заменяют полноценное лечение, назначенное врачом.
Вопрос: Что такое противовирусные препараты и когда их нужно принимать?
Ответ: Противовирусные препараты помогают бороться с вирусом гриппа. Их нужно принимать в первые 48 часов после появления симптомов.
Вопрос: Как отличить грипп от ОРВИ?
Ответ: Грипп обычно протекает тяжелее, чем ОРВИ, и сопровождается более выраженными симптомами, такими как высокая температура, озноб, головная боль и мышечные боли.
| Симптомы | Грипп | ОРВИ |
|---|---|---|
| Температура | Высокая (выше 38°C) | Невысокая (до 38°C) |
| Озноб | Выраженный | Слабый или отсутствует |
| Головная боль | Сильная | Умеренная |
| Мышечные боли | Выраженные | Слабые |
| Слабость | Сильная | Умеренная |
| Противовирусные препараты | Дозировка | Показания |
|---|---|---|
| Осельтамивир | 75 мг 2 раза в день в течение 5 дней | Грипп A и B |
| Занамивир | 10 мг 2 раза в день в течение 5 дней (ингаляционно) | Грипп A и B |
| Амантадин | 100 мг 2 раза в день в течение 5 дней | Грипп A (некоторые штаммы) |
| Римантадин | 100 мг 2 раза в день в течение 5 дней | Грипп A (некоторые штаммы) |
| Месяц | Рекомендации по вакцинации |
|---|---|
| Сентябрь | Начало вакцинации |
| Октябрь | Пик вакцинации |
| Ноябрь | |
| Декабрь-Февраль | Вакцинация по эпидемическим показаниям |
| Мера профилактики | Описание |
|---|---|
| Вакцинация | Ежегодная прививка от гриппа |
| Мытье рук | Регулярное мытье рук с мылом |
| Использование антисептиков | Обработка рук антисептиком |
| Ношение маски | Использование маски в общественных местах |
| Избегание контакта с больными | Ограничение контакта с людьми с симптомами гриппа |
| Укрепление иммунитета | Здоровый образ жизни, правильное питание, физическая активность |
